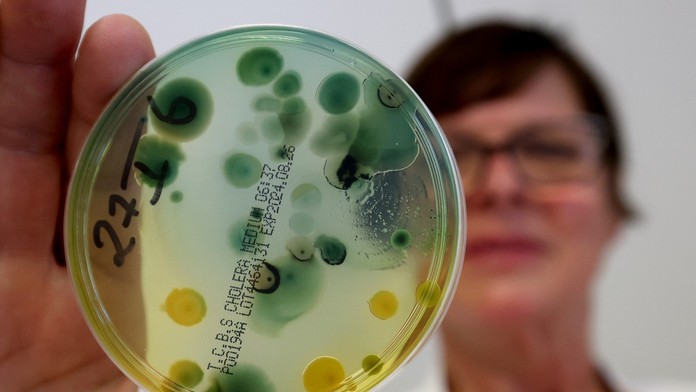
V pobrežných oblastiach dvoch európskych morí sa premnožila nebezpečná baktéria

V pobrežných oblastiach dvoch európskych morí sa premnožila nebezpečná baktéria
Baktérie rodu Vibrio môžu spôsobovať rôzne ochorenia, z ktorých najznámejšie sú cholera, vibrióza a infekcie spôsobené baktériou Vibrio parahaemolyticus.
Európske centrum pre prevenciu a kontrolu chorôb (ECDC) varuje pred zvýšeným výskytom baktérie Vibrio v pobrežných oblastiach Baltského aj Čierneho mora.
„Baktérie prirodzene žijú v slaných pobrežných vodách, kde sa mieša slaná a sladká voda, najmä pri vysokých teplotách a nižšej slanosti. Tieto podmienky sú v dôsledku zmeny klímy v niektorých častiach Európy čoraz častejšie,“ varovalo ECDC v tlačovej správe.

Najviac sa šíri vo vodách s nízkou slanosťou
Hoci infekcie Vibrio sú v Európe naďalej pomerne zriedkavé, v posledných rokoch bol zaznamenaný nárast vo viacerých severných krajinách pozdĺž Baltského mora. Tento jav bol obzvlášť viditeľný v lete pri dlhších vlnách horúčav a vyšších teplotách vody.
V rámci Európy je najhoršia situácia v Čiernom mori, ktoré má nižšiu slanosť a voda sa počas leta zároveň ohrieva na vyššie teploty ako v Baltskom mori.
Spôsobuje choroby a infekcie
Baktérie rodu Vibrio môžu spôsobovať rôzne ochorenia, z ktorých najznámejšie sú cholera, vibrióza a infekcie spôsobené baktériou Vibrio parahaemolyticus.
Keď sa človek nakazí baktériou z konzumácie tepelne neupravených morských plodov, príznakmi sú zvyčajne vodnatá hnačka, bolesti brucha, nevoľnosť, zvracanie, horúčka a zimnica.
Prečítajte si tiež:
Pri plávaní vo vode s veľkým množstvom baktérie hrozí infekcia ucha a kontakt s otvorenou ranou spôsobuje kožné príznaky, ako je začervenanie, opuch a bolesť v postihnutej oblasti.
Ak sa infikovaná otvorená rana nelieči, hrozia vážnejšie problémy, v najhoršom prípade môžu vyústiť do sepsy alebo dokonca do amputácie končatiny.
Vodárne varujú pred nebezpečnou baktériou. Práve v lete je sezóna legionely. Viac sa dozviete z archívnej reportáže v priloženom videu.
Práve sa číta
Sledujte Televízne noviny vo full HD a bez reklám na Voyo





































